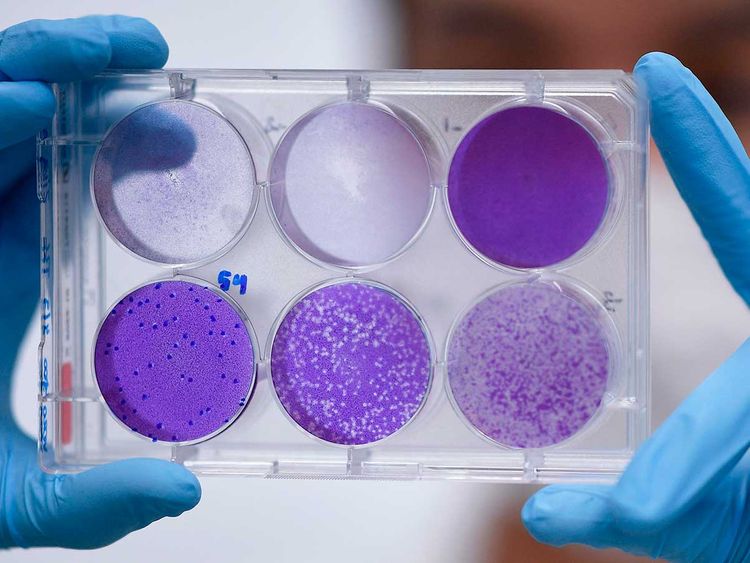

A vaccine that’s been used to prevent tuberculosis is being given to health-care workers in Melbourne to see if it will protect them against the coronavirus.
The bacillus Calmette-Guerin, or BCG, shot has been used widely for about 100 years, with a growing appreciation for its off-target benefits. Not only is it a common immunotherapy for early-stage bladder cancer, it also seems to train the body’s first line of immune defense to better fight infections.